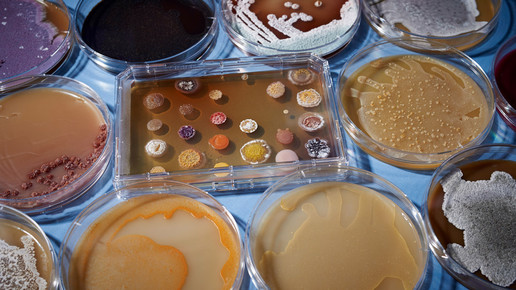

Antibiotika immer häufiger nutzlos
Immer häufiger gibt es gegen resistente Bakterien kein einziges wirksames Medikament mehr. Der Anteil von Patienten mit dem Atemwegs-Keim Klebsiella pneumoniae, denen auch Reserve-Antibiotika wie die Carbapeneme nicht halfen, sei in Europa binnen vier Jahren von 6,2 auf 8,1 Prozent gewachsen, berichtete das Europäische Präventionszentrum ECDC. Gefährliche Resistenzen nehmen demnach generell weiter zu. Doch es gebe auch positive Trends, sagte die amtierende ECDC-Direktorin Andrea Ammon.
„Acht Prozent bedeutet, dass von 100 Patienten acht praktisch nicht mehr behandelbar sind“, sagte Ammon. „Und das sind einfach acht zu viel.“ Im Jahr 2015 seien europaweit rund 9100 Patienten betroffen gewesen. Sie seien nicht „in jedem Fall dem Tod geweiht“. Doch steige das Risiko und Ärzte hätten praktisch keine Optionen zur Behandlung.
Noch sind dies nach den Daten des ECDC seltene Extremfälle. Doch waren 2015 bereits mehr als ein Drittel der untersuchten K.-pneumoniae-Keime gegen mindestens ein Antibiotikum resistent. Das heißt, dass Ärzte zumindest Alternativen suchen mussten.
Einen ähnlichen Trend meldet das Präventionszentrum für das Bakterium Escherichia coli, einen der häufigsten Verursacher von über die Blutbahn verbreiteten Infektionen. Es gebe eine erhebliche Zunahme von Fällen, in denen das Bakterium gegen einzelne oder auch gegen eine Kombination von modernen Antibiotika resistent sei.
Anders sieht es bei den seit Jahren mit großer Sorge betrachteten MRSA-Erregern aus, resistenten Bakterien vom Typ Staphylococcus aureus: Sie wurden 2015 europaweit deutlich seltener festgestellt als noch 2012. Viele Länder hätten gezielt Maßnahmen ergriffen und Erfolg gehabt, sagte Ammon. „Daran kann man sehen, dass es möglich ist, einen solchen Trend nicht nur zu stoppen, sondern umzukehren. Das heißt, es besteht überhaupt kein Anlass zu verzweifeln.“
In Europa laufen seit Jahren Kampagnen, um die Ausbreitung resistenter Keime einzudämmen. Ein Grund für die Resistenzen ist der falsche Einsatz von Antibiotika: Sie werden zu häufig verordnet oder nicht richtig eingenommen. Bakterien können sich in der Folge so anpassen, dass ihnen die Wirkstoffe nichts mehr anhaben. Sind sie gegen mehrere oder alle antibakteriellen Medikamente gewappnet, kann es für Patienten gefährlich werden. Experten führen bis zu 25.000 Todesfälle in Europa jährlich auf Resistenzen zurück.
Gegenmaßnahmen setzen nach Ammons Worten auf verschiedenen Ebenen an. Antibiotika sollten nur verschrieben und genommen werden, wenn es nötig ist. Krankenhäuser müssten streng auf Hygiene achten und Patienten mit resistenten Keimen von anderen Kranken abschirmen. Das Bewusstsein „ist gewachsen, aber es reicht noch nicht“. Anlass der Veröffentlichung war der neunte Europäischer Antibiotikatag (European Antibiotic Awareness Day).

APOTHEKE ADHOC Debatte